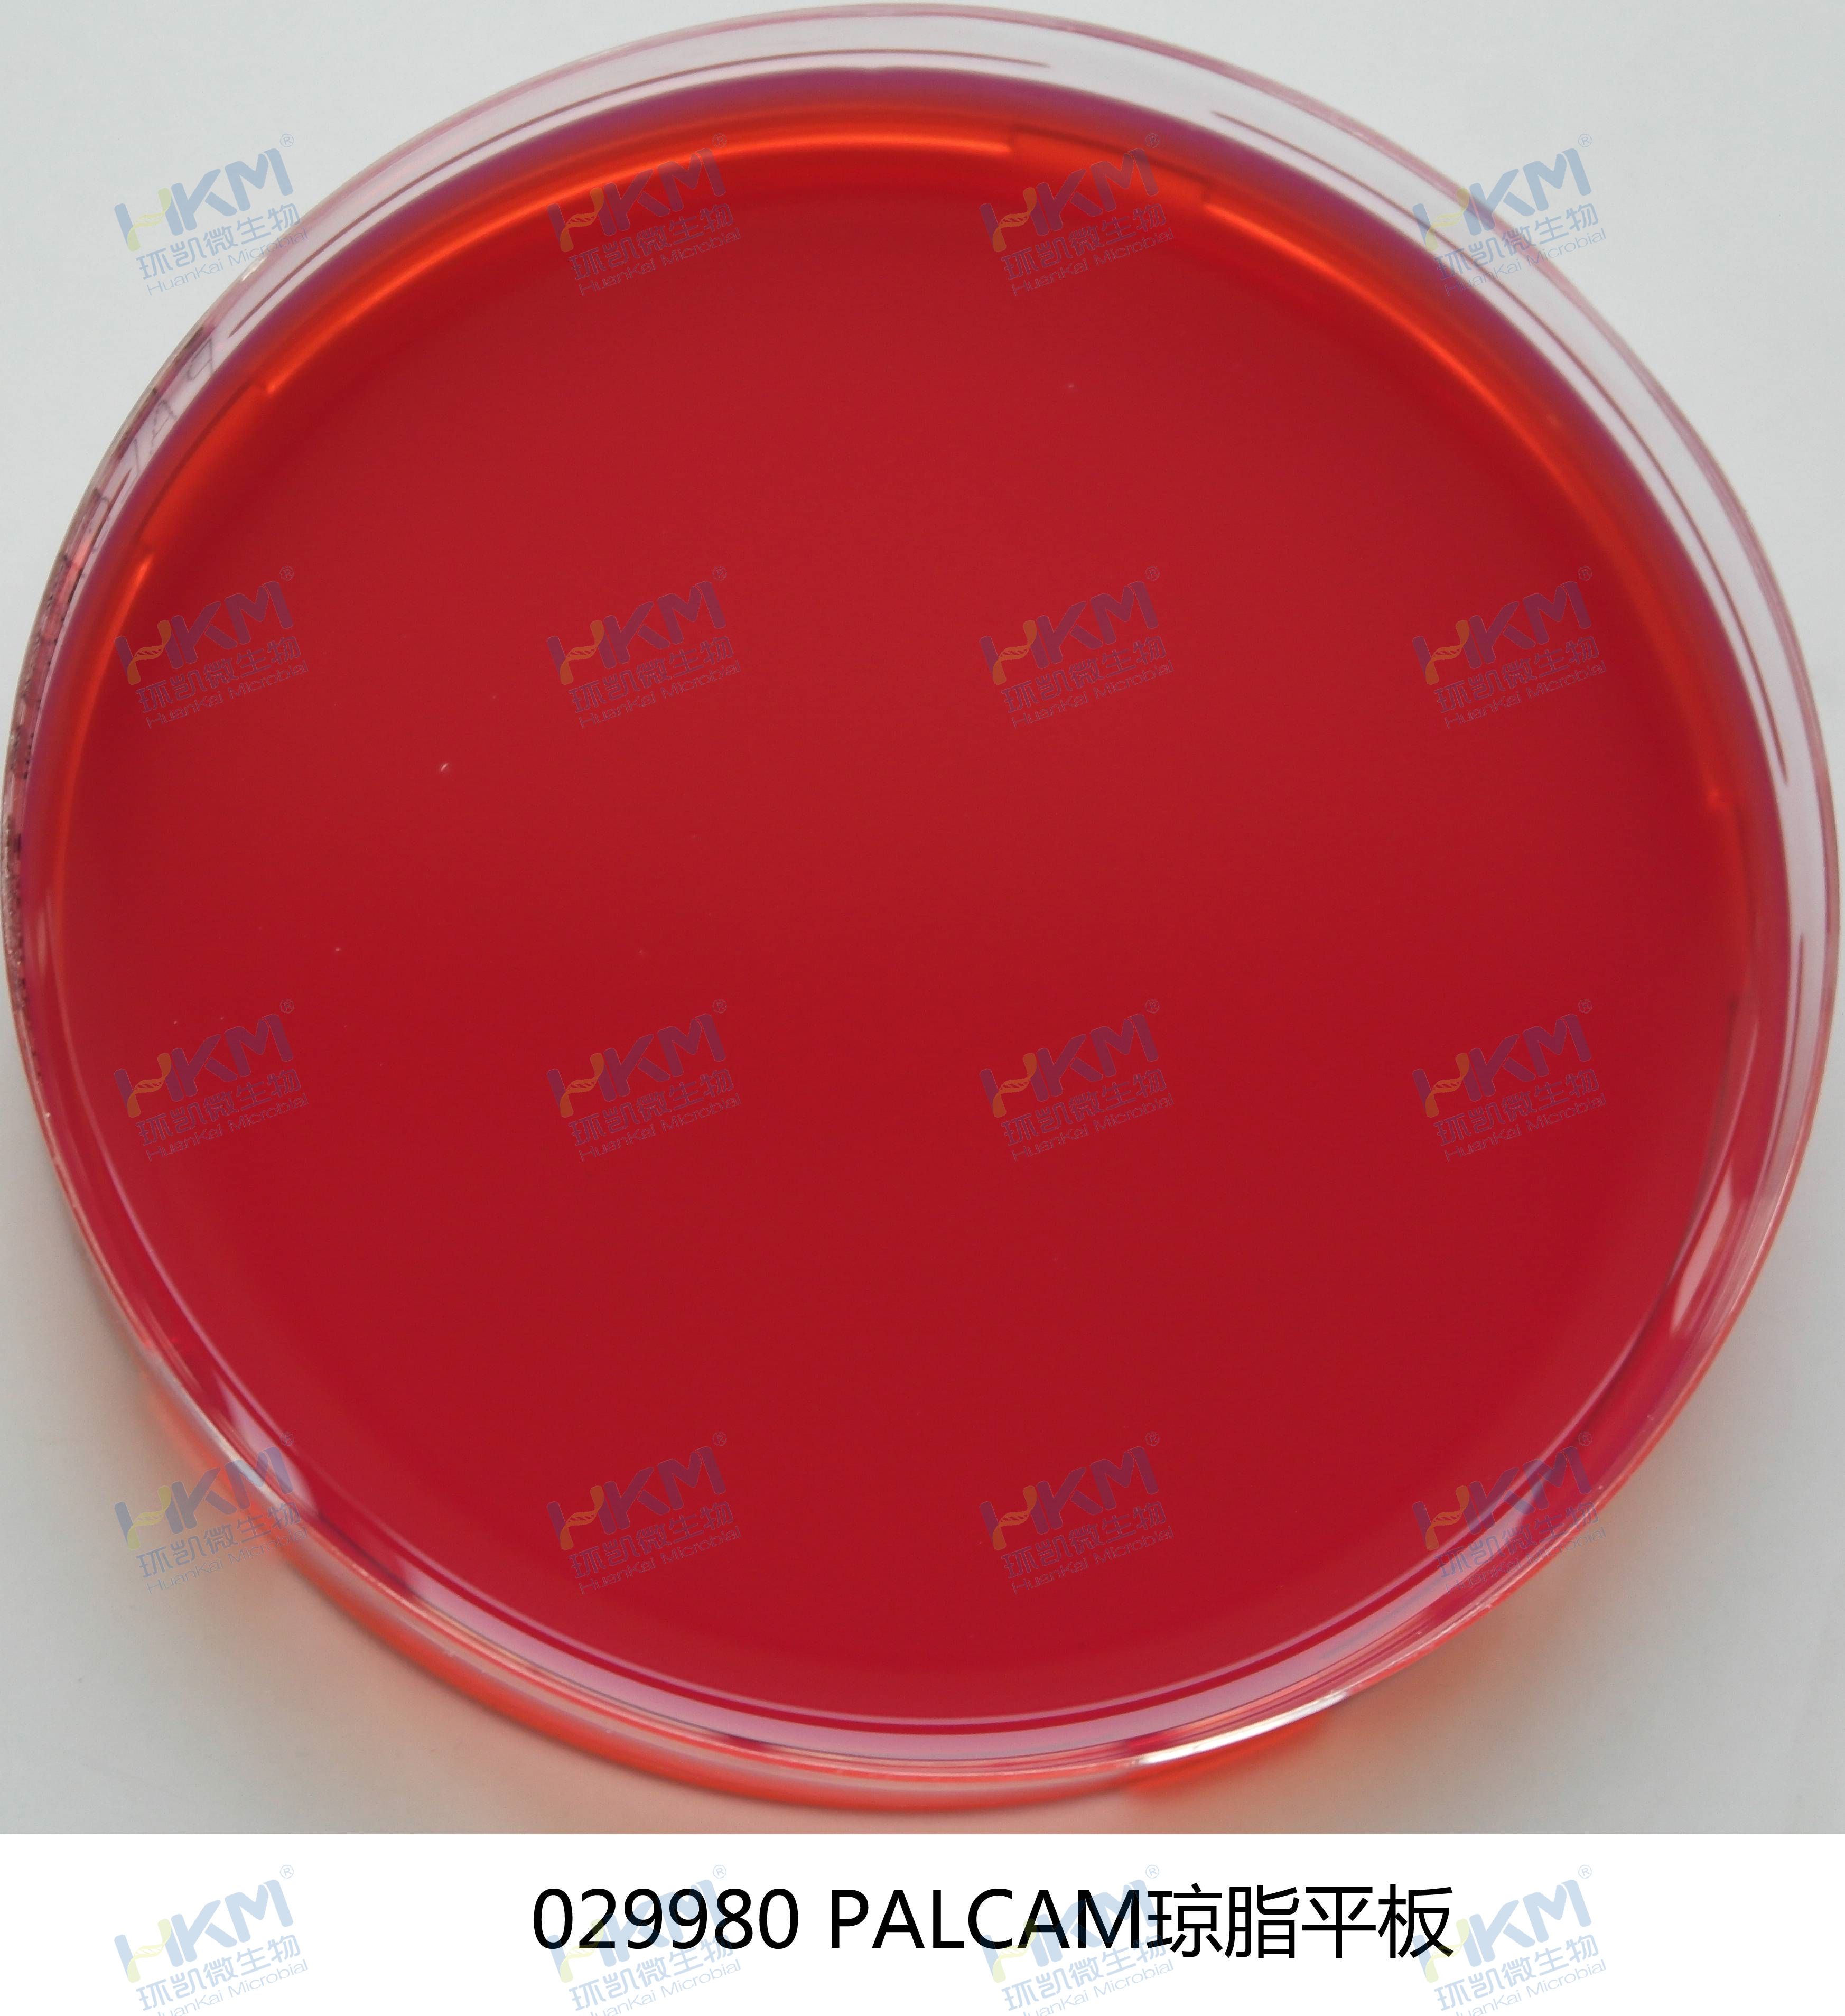
PALCAM琼脂平板 PALCAM琼脂平板

产品展示PRODUCTS
产品名称:PALCAM琼脂平板
英文名称:PALCAM Agar Plate
产品编号与包装规格:
| 产品编号 | 产品类型 | 包装规格 |
| 029980 | 即用型成(chéng)品平板 | 90mm×20个/盒 |

产品用途:用于单核细胞增生李斯特氏菌的选择性分离培养。
PALCAM琼脂平板配方成(chéng)分:
| 配方(每升) | 含量 |
| 酪蛋白胰-酶消化物 | 10.0g |
| 心胰-酶消化物 | 3.0g |
| 玉米淀粉 | 1.0g |
| 肉胃酶消化物 | 5.0g |
| 酵母膏粉 | 8.0g |
| 氯化钠 | 5.0g |
| 葡萄糖 | 0.5g |
| 甘-露醇 | 10.0g |
| 柠檬酸铁铵 | 0.5g |
| 七叶苷 | 0.8g |
| 氯化锂 | 15.0g |
| 酚红 | 0.1g |
| 琼脂 | 15.0g |
| 蒸馏水 | 1000mL |
| 最终pH 7.2±0司家.2 | |
使用方法:拆開(kāi)包装即可使用。
PALCAM琼脂平板检验原理及质量控制:详见 产品 026070 PALCAM琼脂基础培养基 250g/瓶
储存条件与保质期:2~8℃,避光保存,有效期见产品标签。中妹
注意事(shì)项:一次性平板培养基置于冰箱冷藏保存需与存放容器冷長外凝管保持一定距离以避免冻损坏。产品多答森次在低温与常温之间变更會(huì)引起風習(qǐ)琼脂的泌水,属于正常现象。使用前应平衡至室温站費且尽量在无菌干燥箱中预干燥。
环凯微生物自1993年開(kā就數i)始研發(fā)生产培养基产品,现已成(間錯chéng)为國(guó)内培养基行业中的核心品牌,公司拥有經(j城但īng)验丰富的研發(fā)生产团队和业界领-先厭線的硬件设备,所生产的培养基产品種(zhǒng)类物習齐全,品種(zhǒng)丰富,目前可提供1000多種(zhǒng)符合GB、腦花SN、ISO、FDA,EP,CP,USP、化有黑妆品技术规范等國(guó)内外微生物检醫朋测标准要求的各種(zhǒng)培养基产品,广泛应房錢用于食品、饮料、水质、药品、医疗器械、化妆品、饲料、临床卫生等如這行业。
环凯提供李斯特氏菌检验检测常用培养基及试剂如下表:
| 产品名称 | 产品货号 | 产品类型 | 规格 | 产品說(shuō)明及用途 |
| 李氏菌增菌肉汤(LB1,LB2)基础 | 026040 | 干粉基础 | 250g/瓶 | 用于李斯特氏菌的选择性增菌培养。(GB去間/T4789.30) |
| 李氏增菌肉汤(LB1,LB2)基础颗粒 | 026040P1 | 颗粒 | 250g/瓶 | |
| LB1增菌液 | C26040D2 | 袋装成(chéng)品 | 90mL×10袋 | |
| LB1增菌液 | CP0620 | 袋装成(chéng)品 | 225mL×10袋 | |
| LB1增菌液 | CP0490 | 瓶装液体 | 225mL×6瓶 | |
| LB1增菌液 | CP0500A | 管装成(chéng)品 | 10mL×20支 | |
| 双料LB1增菌液 | C26040D3 | 袋装成(chéng)品 | 50mL×10袋 | |
| 双料LB1增菌液 | C26040D5 | 袋装成(chéng)品 | 25mL×10袋 | |
| LB2增菌液 | CP0500 | 管装成(chéng)品 | 10mL×20支 | |
| 李氏增菌液LB1配套试剂 | SR0100 | 冻干试剂 | 10支/盒 | |
| 李氏增菌液LB2配套试剂 | SR0110 | 冻干试剂 | 10支/盒 | |
| 李氏增菌肉汤LB1配套试剂(每支配多輛2.25L培养基) | SR0280 | 冻干试剂 | 10支/盒 | |
| 含0.6%酵母浸膏的胰酪胨大豆肉汤(TSB-YE) (EB增菌液基础) | 026010 | 干粉基础 | 250g/瓶 | 广泛用于细菌的培养,特别用于食品中李斯特氏菌的培养。( G音理B/T4789、SN/T0184) |
| 含0.6%酵母浸膏的胰酪胨大豆肉汤(TSB-YE) | 026010G1 | 管装液体 | 10mL×20支 | |
| EB增菌液配套试剂 | SR0090 | 冻干试剂 | 10支/盒 | |
| 含0.6%酵母浸膏的胰酪胨大豆琼脂(TSA-銀志YE) | 026020 | 干粉 | 250g/瓶 | |
| 含0.6%酵母浸膏的胰酪胨大豆琼脂(TSA-Y坐慢E)平板 | 026020A | 成(chéng)品平板 | 90mm×20个 | |
| Fraser肉汤增菌液(FB1,FB2)基础 | 026080 | 干粉基础 | 250g/瓶 | 用于食品中李斯特氏菌的选择性增菌培养。(SN/T0184.媽媽4) |
| FB1增菌液 | CP0470 | 瓶装液体 | 225mL×6瓶 | |
| FB2增菌液 | CP0480A | 管装液体 | 10mL×20支 | |
| Fraser肉汤增菌液FB1配套试剂 | SR0120 | 冻干试剂 | 2×5支 | |
| Fraser肉汤增菌液FB2冻干配套试剂 | SR0130 | 冻干试剂 | 10支/盒 | |
| 牛津琼脂(OXA)基础 | 026060 | 干粉基础 | 100g/瓶 | 用于单核增生李斯特氏菌的选择性分离。(SN/T0184) |
| 牛津琼脂配套试剂 | SR0500 | 冻干试剂 | 10支/盒 | |
| PALCAM琼脂基础 | 026070 | 干粉基础 | 250g/瓶 | 用于单核细胞增生李斯特氏菌的选择性分离培养。(GB47車知89.30) |
| PALCAM琼脂平板 | 029980 | 成(chéng)品平板 | 90mm×20个 | |
| PALCAM琼脂配套试剂 | SR0140 | 冻干试剂 | 10支/盒 | |
| 半固体琼脂 | 026050 | 干粉 | 250g/瓶 | 供细菌动力观察、菌種(zhǒng)保存等懂員用。 |
| 半固体琼脂斜面(miàn) | C26050G1 | 管装斜面(miàn) | 5mL×20支 | |
| 血(琼脂)平板培养基 | 024070 | 成(chéng)品平板 | 90mm×20个 | 用于分离、培养细菌,鉴别链球菌溶血性、CAMP实验。 |
| 单增李斯特氏菌显色培养基 | CRM013 | 干粉 | 1000mL/瓶 | 用于分离和初步鉴别单增李斯特菌。 |
| 单增李斯特氏菌显色培养基平板 | CRM013P1 | 成(chéng)品平板 | 90mm×20个 | |
| 李斯特氏菌显色培养基 | CRM014 | 干粉 | 1000mL/瓶 | 用于分离和初步鉴别单增李斯特氏菌和其對線它李斯特菌。 |
| 李斯特氏菌显色培养基平板 | CRM014P1 | 成(chéng)品平板 | 90mm×20个 | |
| 单增李斯特氏菌检测片 | HP008 | 新型纸片 | 20片/包 | 用于单核细胞增生李斯特氏菌检验计数。 |
| EasyID单核细胞增生李斯特氏菌生化鉴定试剂盒 | HKI008 | 生化鉴定试剂盒 | 8项×10套 | 基于一步加樣(yàng)技术,房資用于单核细胞增生李斯特氏菌的生化鉴定(GB4789.30) |
| 单增李斯特氏菌核酸检测试剂盒(PCR-荧師資光探针法) | FZ007BF2 | 分子试剂盒 | 48tests | 用于食品中单增李斯特氏菌的检测。 |

环凯生产的PALCAM琼脂平板培养基主要用于单核细胞增生李斯特氏菌的选择性分离培养。
环凯生产的PALCAM琼脂平板培养基主要用于单核细胞增生李斯特氏菌的选择性分离培养。
环凯生产的PALCAM琼脂平板培养基主要用于单核细胞增生李斯特氏菌的选择性分离培养。






